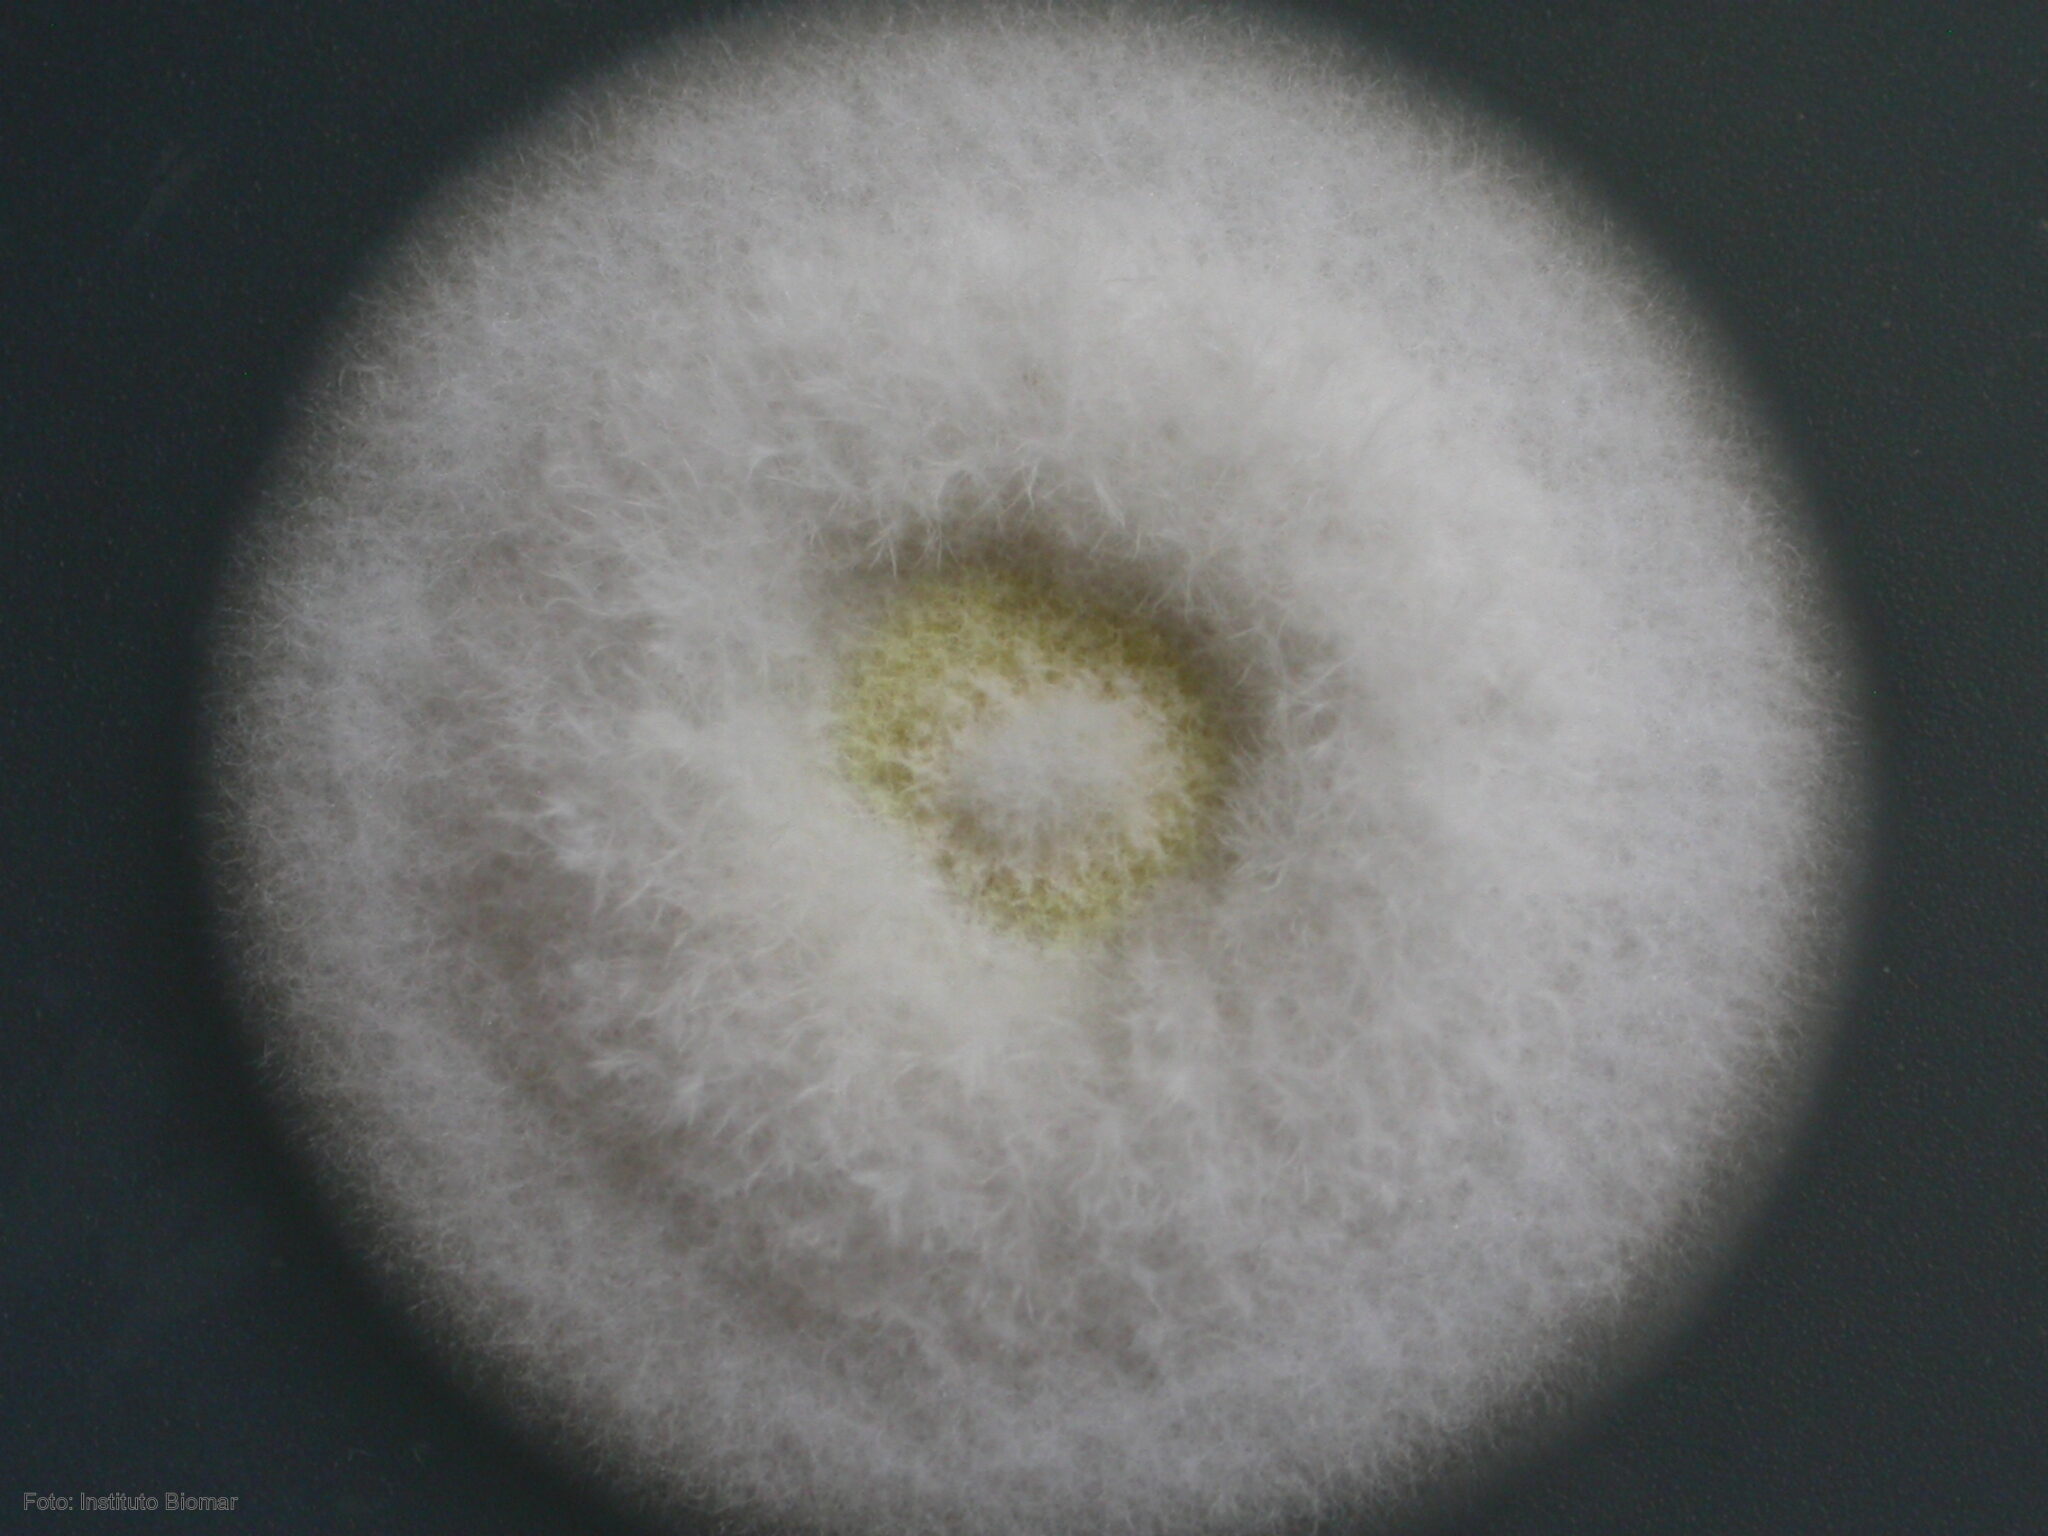
Una empresa de León testa un compuesto de un hongo marino para la leucemia

Naturaleza

Científicos de Salamanca publican en Nature un revolucionario estudio sobre microorganismos y plantas

El río Tajo será navegable todo el año entre la presa de Cedillo y la desembocadura de la rivera Sao Domingo

El proyecto de restauración ambiental de Ampros en los Pozones concluye con la plantación de 2.000 árboles